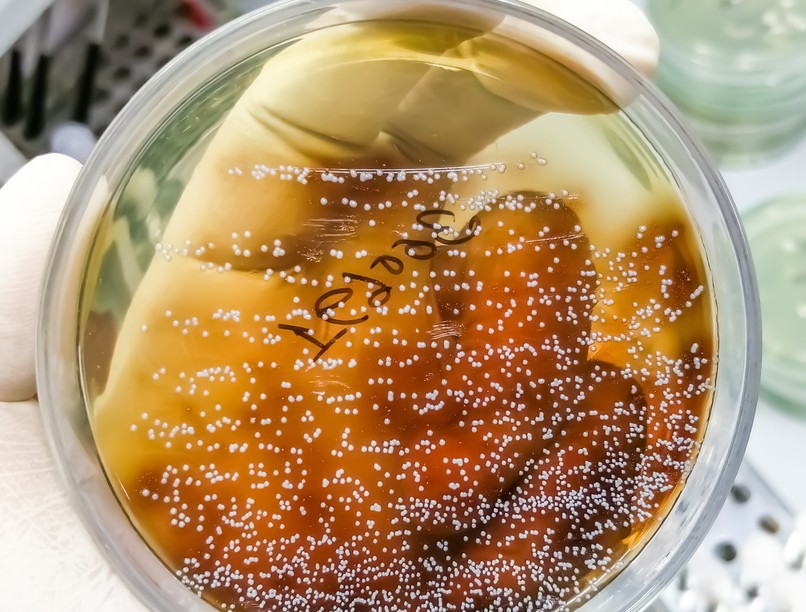
rák, daganat, gomba, mikrobiom, candida, kutatás

A több ezer daganatmintát vizsgáló tanulmányok az eddigi legegyértelműbb kapcsolatot mutatják a rák és a gombák között - de további kutatásokra is szükség van.
Évek óta egyre több a bizonyíték arra, hogy a baktériumok kapcsolatban állnak a rákkal, sőt, néha döntő szerepet játszanak a rák kialakulásában. Most a kutatók hasonló kapcsolatot találtak egy másik mikroorganizmustípussal: a gombákkal.
A különböző ráktípusok daganatai különböző mikroszkopikus vagy egysejtű gombafajokat tartalmaznak, ezeknek a fajoknak a vizsgálata egy napon hasznos lehet a rák diagnosztizálásában vagy a lefolyásának előrejelzésében - derül ki a Cell című szaklapban szeptember 29-én megjelent két tanulmányból (1,2).
"Lenyűgöző a gombákat a rákos megbetegedések környezetében vizsgálni" - mondja Ami Bhatt, a kaliforniai Stanford Egyetem mikrobiom-specialistája, hozzátéve, hogy a tanulmányok csak arra utalnak, hogy van összefüggés a gombafajok és bizonyos rákos megbetegedések között - azt nem mutatják ki, hogy a gombák közvetlenül felelősek-e a rák kialakulásáért.
35 ráktípust vizsgáltak meg
A baktériumokhoz hasonlóan a gombás mikroorganizmusok is az emberi mikrobiom kényes egyensúlyú részét képezik. Annak megértése érdekében, hogy ez az összetétel hogyan változhat meg a rákos betegeknél, Lian Narunsky Haziza, az izraeli Rehovotban található Weizmann Tudományos Intézet rákbiológusa és kollégái több mint 17 000, 35 ráktípust képviselő szövet- és vérmintában katalogizálták a gombapopulációkat(1).
A várakozásoknak megfelelően a gombák, köztük számos élesztőgombafaj jelen volt a vizsgálatba bevont valamennyi ráktípusban, de egyes fajok a rákbetegségtől függően eltérő kimenetelhez kapcsolódtak.
Például a Malassezia globosa, egy olyan gomba jelenléte, amelyet korábban a hasnyálmirigyrákkal hoztak összefüggésbe, a kutatók szerint a mellrák esetében jelentősen csökkent túlélési arányhoz kapcsolódott.
A daganatokban lévő baktériumok jellemzésével Narunsky Haziza és munkatársai úgy találták, hogy a legtöbb gombafaj bizonyos baktériumfajokkal hajlamos volt együtt élni, ami azt jelenti, hogy a daganat a gombák és a baktériumok növekedésének egyaránt kedvezhet - ellentétben a tipikus környezetekkel, ahol a gombák és a baktériumok versengenek a közös erőforrásokért.
Egy másik tanulmányban(2) Iliyan Iliev, a New York-i Weill Cornell Medicine immunológusa és kollégái gyomor-bélrendszeri, tüdő- és emlődaganatokat vizsgáltak, és megállapították, hogy ezek általában Candida, Blastomyces és Malassezia gombákat tartalmaznak.
A Candida magasabb szintje a gyomor-bélrendszeri tumorsejtekben a gyulladást elősegítő nagyobb génaktivitással, a nagyobb arányú áttétképződéssel és az alacsonyabb túlélési arányokkal függött össze - állapították meg a kutatók.
"A daganatban lévő gombasejtek jellemzése olyan, mint tűt találni a szénakazalban" - mondja Deepak Saxena, a New York-i Egyetem mikrobiológusa, aki a gombák és a rák kapcsolatát kutatta. "A mintától függően általában csak körülbelül egy gombasejt jut minden 10 000 daganatsejtre" - mondja.
Ráadásul a megtalált gombák igen elterjedtek, így vigyázni kell, nehogy azokkal szennyeződjenek a minták - mondja Iliev. Ez azt jelentette, hogy a kutatóknak nagy gondot kellett fordítaniuk arra, hogy kiszűrjék az eredményeikből a szennyeződésre utaló esetleges bizonyítékokat vagy a gombás DNS hamis egyezéseit. Iliev és kollégái például a test minden részéből származó tumorszövetekben találtak egy olyan DNS-töredéket, amelyet tévesen portobello gombaként (Agaricus bisporus), egy gyakori ehető gombaként azonosítottak.
Mindkét kutatócsoport a szövet- és vérminták nagy részét adatbázisokból szerezte be, így a minták gyűjtésekor nem a gombás szennyeződés minimalizálása volt a cél - mondja Bhatt. Bár a kutatók olyan módszereket dolgoztak ki, amelyekkel a szekvenálási adatokból kiszűrték az esetleges szennyeződéseket, szeretnék, ha az eredményeket steril környezetben vett minták felhasználásával megismételnék.
Gyuladást okozva rontanak a rákbetegségen a gombák?
Bár ez a kutatás az eddigi legegyértelműbb kapcsolatot biztosítja a rák és a gombák között, Saxena szerint további vizsgálatokra van szükség annak megértéséhez, hogy a gombák hozzájárulhatnak-e a rák progressziójához, például gyulladást okozva, vagy azzal, hogy az előrehaladott daganatok olyan lakókörnyezetet teremtenek, amely elősegíti a gombasejtek térnyerését.
E kérdések megválaszolásához a kutatóknak egyidőben kell vizsgálniuk egy-egy ráktípust, és a laboratóriumban tenyésztett sejtekkel és állatmodellekkel kell tesztelniük, hogy a gombák az egészséges sejteket rákosodásra ösztönzik-e - mutatott rá Charis Eng, az ohiói Cleveland Clinic rákgenetikusa.
Amint a kutatók jobban megértik a gombák rákban betöltött szerepét, talán képesek lesznek olyan terápiás szerek vagy probiotikumok kifejlesztésére, amelyek szabályozzák a gombapopulációkat, ami segíthet megállítani a rák progresszióját - mondja Eng.
Olvasta már?
- Ezekkel a szokatlan tünetekkel jelez előre a hasnyálmirigyrák
- Boldogsághormon: kiderült, hogy szívgyógyító tulajdonságokkal is rendelkezik
- A mellrák nem egyetlen betegség: tizenegy altípusa van
- Mit tenne, ha kapna plusz öt életévet? Egy új kutatás szerint ezt!
- Ha ezen az oldalán fekszik, gyorsabban hat a lenyelt gyógyszer
Candida-fertőzés: oka, tünete és kezelése
Hivatkozások:
https://doi.org/10.1038/d41586-022-03074-z
(1) Narunsky-Haziza, L. et al. Cell https://doi.org/10.1016/j.cell.2022.09.005 (2022).
(2) Dohlman, A. B. et al. Cell https://doi.org/10.1016/j.cell.2022.09.015 (2022).
Kövesse az Egészségkalauz cikkeit a Google Hírek-ben, a Facebook-on, az Instagramon vagy a X-en,Tiktok-on is!